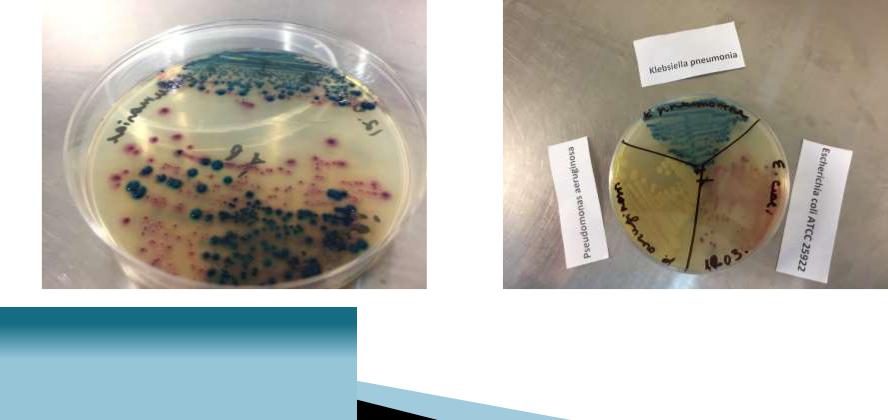

Материал: lektsia_FIZIOLOGIYa_MIKROORGANIZMOV_fiziologia-2020
•транспортные (консервирующие) – с. Кери-Блэра, с. Стьюарта и др.;
•хромогенные среды – хромагар, уриселект и др.
K. pneumonia

Типы энергетического метаболизма (биологического окисления) у гетеротрофов
Дыхание (окислительный |
|
Брожение |
|
(ферментативный |
|
метоболизм) – АТФ |
|
|
|
метаболизм) – АТФ |
|
образуется в основном |
|
|
|
образуется только путем |
|
путем окислительного |
|
|
|
субстратного |
|
фосфорилирования |
|
|
|
фосфорилирования |
|
|
|
|
|
|
|
аэробное |
|
анаэробное |
|
|
|

Дыхание
– способ получения энергии в результате окисления органических субстратов (преимущественно углеводов), при котором конечным акцептором электронов
и ионов водорода является кислород.
|
|
|
|
|
|
|
|
|
|
|
|
Анаэробное |
||
Аэробное |
|
- акцептором электронов или |
||
- конечным акцептором |
|
ионов водорода являются |
||
электронов или ионов |
|
неорганические |
||
водорода является |
|
соединения,содержащие |
||
молекулярный кислород |
|
«связанный» кислород(нитраты, |
||
|
|
нитриты и др.) |
||
|
|
|
|
|

Облигатные аэробы |
|
Облигатные |
|
Факультативные |
|
анаэробы |
|
анаэробы |
|
|
|
|
||
|
|
|
|
|
|
|
|
|
|

Облигатные аэробы
растут и размножаются только в присутствии кислорода, используют кислород для получения энергии путем кислородного дыхания
Строгие аэробы
Имеют системы защиты от токсического действия молекулярного О2 (ферменты групп пероксидазы, каталазы, супероксиддисмутазы). Кол-во О2 должно быть не менее 20%;
Р.aeruginosa
M.tuberculosis
некоторые подвиды р.Brucella
Микроаэрофилы
растут при пониженном парциальном давлении — 4-6% кислорода
Хеликобактеры, кампилобактеры, лептоспиры, листерии, боррелии, актиномицеты.